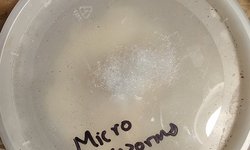

The SCTFS 4th Annual Fall Auction October 2025
An in-person auction, created by Matt_Korsun
You are viewing only lots from BraintreeAqua
Search and filter
Lot 238-8
6x Blue Eye Longfin Bristlenose Plecos
SOLD

Plecostomus
Lot 238-7
Banana Worms
SOLD

Live food cultures
Lot 238-6
Walter Worms
SOLD

Live food cultures
Lot 238-5
Microworms
SOLD
Live food cultures
Lot 238-4
Neolamprologus Multifaciatus Group
SOLD

Cichlids - Rift Lake
Lot 238-2
6x Blue Eye Longfin Bristlenose Plecos
SOLD

Plecostomus